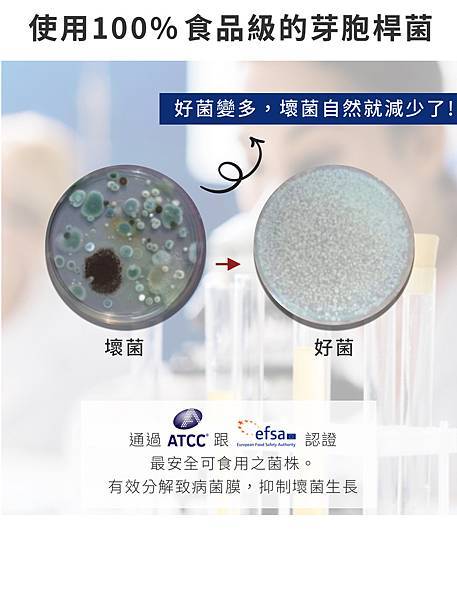
530069fe-7-居家抗敏益生菌-可食用芽孢桿菌安全無慮 530069fe-7-居家抗敏益生菌-可食用芽孢桿菌安全無慮

Chef Clean淨毒五郎
2015年創立自有品牌
以「植物原料開發家庭清潔用品」
取代市場上以石油提煉的清潔用品。
💯環境友善 ECO FRIENDLY
拒絕使用、添加任何會危害環境
亦或產生環境賀爾蒙等危害化學物質。
💯親膚安全 SKIN FRIENDLY
拒絕使用會傷害人體肌膚
或造成敏感性患者擔憂成分。
💯溫和有效 EFFECTIVE CLEANER
成分皆以安全、有效為基準製成
只提供你/妳所需要的成分。

應該很多人都有聽過Chef Clean淨毒五郎這個品牌吧!
除了網路銷售外,
也越來越多實體通路可以試用到他家的商品
例如:藥局/量販店等等,都可以參考這邊的販售點
更特別的是!Chef Clean淨毒五郎為了致力達成全方位綠色清潔用品,
有效徹底實踐「重複使用」的力量
在全台各處與許多店家合作「無包裝補充店」>>這裡
以填充方式,重複利用瓶器,
以避免擺脫一次性的浪費,減少製造出任何新塑膠!
就是這麼友善又貼心的品牌
讓人忍不住一再回購支持!
當然商品的效果,也是有口皆碑囉
以下就要來分享我的淨毒五郎各品項使用心得!
/如有較專業的商品成分及使用問題也可
加入淨毒五郎LINE客服帳號作詢問/

因為淨毒五郎的品項較多
這邊幫大家設好目錄,
---請點名稱可直達介紹---
----- 我是文章導讀目錄 -----
🌱蔬果清潔劑
🌱碗盤清潔劑
🌱除臭噴霧
🌱衣物驅蟎噴霧
🌱防蟎保潔枕墊(已停售)
🌱消臭洗衣精
🌱酵素手洗精
🌱洗衣槽清潔劑
🌱益菌生嬰兒洗髮沐浴慕斯(已停售)
🌱胺基酸抗菌洗手慕斯
🌱廚房去油污清潔慕斯
🌱長效抗菌噴霧+Plus升級版
🌱除水垢浴室清潔劑
🌱羽絨專用洗劑(已停售)
🌱除臭地板清潔劑
🌱NEW深層除黴凝膠
🌱益菌生保濕沐浴露(已停售)
🌱控油洗髮精(已停售)
----- 點名稱直達介紹 ---
日常清潔用品的選擇五花八門,
要踏入一個新品牌,
對於某些捧友來說可能會覺得有些麻煩?
畢竟用慣了,也好用,那為什麼要換?
但若是這項商品,對環境更友善,對肌膚更無害,
效果也更好!您會心動嗎?
想當初我第一次接觸淨毒五郎,
就是用了他家的"蔬果清潔劑"
也因為一試成主顧,
接著就一步一步被他家其他商品給攻陷啦!

這罐蔬果清潔劑,
顧名思義就是拿來清潔蔬果表面
我們肉眼難以辨識的脂溶性髒污
但後來才知道,原來他還能拿來洗奶瓶呢!
以食品洗劑級規格製造
主原料為南瓜酵素、小麥、玉米🌽
等植物來源,就算有殘留,
或是不小心誤食也無害,
這就是為什麼很多媽媽,會拿這罐來洗
寶貝的奶瓶/奶嘴/固齒器的原因!
而且它的低泡沫設計,非常好清洗!


使用在水果及菜葉上的方式很簡單
就是 噴浸泡2-3分搓洗沖掉即可
因為太簡單,
我常常會使喚我女兒去洗水果
小妞就會很有成就感,
殊不知我是對淨毒家的商品很放心😌

為什麼要用蔬果清洗劑來洗蔬果呢?
因為蔬果上的脂溶性農藥是清水無法去除的
且蔬果上的髒污和蟲卵🐛😰
沒洗乾淨,真的能安心讓家人食用嗎?
像我最喜歡吃玉女小番茄,
如果吃之前沒用這個噴洗一下
我可是沒辦法放開心胸享用!

無籽葡萄也很欠噴,
吃之前也一定要先用蔬果清潔劑噴洗一番

再分享另個反差比較大的用途!
就是它居然可以拿來殺小強!
不是因為它毒,
而是因為小強身上是油的,
碰到界面活性劑會無法呼吸!
雖然淨毒家用的介面活性劑
是植物性的,但小強還是怕怕!
現在家裡少了這罐都不知道怎麼洗蔬果了!
這麼好的商品,您一定要試試看!
2020全面升級配方,成分更環保更溫和!
植物介面活性劑成分改為
全APG配方(小麥/玉米/馬鈴薯製作),
因此,顏色會呈現淡淡黃色

其實用噴的很方便
更能清潔到一些不好清的縫隙

像擠奶器,如果我用洗潔劑洗,
用量比較多還要起泡
但用噴的各角度都洗到了

我之前也有把它裝入慕斯瓶過
擠出來的泡沫狀也很方便使用!
和市面上同類型慕斯劑型奶瓶清潔劑相比
我覺得用淨毒五郎更省耶!😆

碗盤清潔劑(香調-無香)
一般市面上的碗盤清潔劑大多都是化學成分!
因為化學的清潔力更強咩!
但淨毒家的碗盤清潔劑是植物原料萃取,
主要成分為:南瓜、葡萄籽、蘆薈、椰子油
並添加低敏配方蘆薈萃取液(2022/3月後改成新配方無葡萄籽成分)
更適合有富貴手問題的捧友使用,
我自己就是富貴手患者,將碗盤清潔劑換成淨毒家後
真的覺得比較舒服

雖然蔬果清潔劑
也可以拿來洗比較不油膩的食器
但面對較油膩的食器,
還是得出動碗盤清潔劑
因為碗盤清潔劑的成分,有包覆油脂的能力
更能快速去除油漬
這就是蔬果清潔劑和碗盤清潔劑的差別
所以家裡還是得要有碗盤清潔劑駐場啦!

也因為Eco Cert認證植物性原料製造
高達97%以上的大自然分解度,
很多人都會拿他家的
碗盤清潔劑洗寵物的碗盤,不用擔心殘留
如此一來,也能讓小孩學著洗自己營養午餐的餐具,
安心又能培養小孩獨立負責的態度

說到淨毒五郎中我最愛的商品NO2
就是衣物手洗精(香調-微風)

我固定放一瓶在浴室,
拿來洗內衣褲,和寶寶的衣物
單純又安全的成分
蛋白酵素, 南瓜酵素, 蘆薈萃取液,
香茅衍生物,椰子油系界面活性劑,
甜菜鹼界面活性劑, APG,純水,香精
用在親膚的貼身衣物,很安心
重點是洗淨力也很強

像沾到醬料的食物髒汙,
去除的效果很不錯!
只要讓洗劑在髒污上稍作停留,
讓蛋白酵素有時間作用
再慢慢加水搓洗
完全洗淨的成功率真的很高!
/去血漬的效果也不錯,但下圖是蕃茄醬不是血啦😅/

有幾次,即便是在外面沾到一段時間的髒污
回家後,將洗劑在髒污上稍作停留
分次加水搓洗,還是都成功了!
所以它已經是我心目中最厲害的手洗精

微風的調香,聞起來有股清新感
聽說很多媽媽都會拿來去除衣物的吐奶味
因為家中寶寶不常吐奶
但實際清洗沾到便便的衣物,效果很不錯!
因為成分安全又親膚,
我甚至也會拿來洗美妝蛋/粉撲和刷具(但畢竟不是專用洗劑請自行評估使用)
一開始只是想試試看,沒想到洗得滿乾淨的
用在臉上時,時不時會聞到這股清新的調香氣味很舒適!

因為是中性洗劑,所以也不會傷毛刷

但若要機洗大量衣物,
還是得使用消臭洗衣精(香調-無香)
因為消臭洗衣精是濃縮成分
用量很省,若是拿手洗精洗衣服,
用量太傷了啦!
所以,洗大量衣物或是要去除臭味
請用消臭洗衣精(香調-無香)
要清洗貼身衣物/寶寶衣物
或是加強清洗食物殘留的污漬或是血漬
請使用衣物手洗精(香調-微風)
成份也會比消臭洗衣精(香調-無香)會更親膚一些

這罐消臭洗衣精(香調-無香)
也是中性洗衣精,不會傷害衣物纖維!
因此也能清洗機能性運動服飾
尤其它的去臭(汗味/霉味/悶臭味...異味)效果特別好
但它不是用香味去壓臭味喔!
是因為添加除臭酵素可以去除臭味,
所以對氣味敏感的人,也能安心使用!
老公辛勤打拼揮汗的衣物,
小屁孩玩瘋後的衣物,
毛小孩的床墊玩偶,
下雨天淋濕悶臭的衣物,
寶寶吐奶噴尿破壞的衣物,
都靠這瓶消臭洗衣精(香調-無香)

濃縮設計,一瓶約可使用三個月!
️無香味,對香氣過敏👌
️用量省(請看商品用法介紹)
️不添加香精和石化柔軟精
️不含導致阻塞透氣纖維原料
️植物萃取成分寶寶也能用
️運動機能排汗商品也能用


洗衣槽清潔劑
不過,說到要把衣服洗好,
洗衣槽的清潔也是很重要的!
因為洗衣槽會累積棉絮、灰塵等污垢
進而產生細菌和異味,
沒定時清洗的洗衣槽細菌數可達馬桶的200倍
所以洗衣槽沒洗乾淨,衣服的乾淨只是表面😱

請不要忽略洗衣槽定期的保養與清洗
無論滾筒和直立式洗衣機,使用方式都一樣
建議使用溫水,瓦解汙垢的效果更好!

出門要體面,又懶得整燙
就得要有這罐衣物除皺噴霧(已停產)

️天然矽油,可撫平衣物纖維

️可形成保護膜,抗菌又除臭


️針對棉、麻、亞麻效果較佳
夏天最多薄棉T和麻料上衣了,
不想每天燙衣服!?
那就一定要入手除皺噴霧

🔸使用方法很簡單:
1.對著衣物皺摺處均勻噴灑2-3下
2.反覆用雙手拉撐皺摺處
3.用手撫平皺紋,穿上自信出門!
衣物驅蟎噴霧
防蟎保潔枕墊(6入組)
是說台灣每3個人就有1個人受過敏問題所苦
但台灣夏天潮濕悶熱的氣候型態,
又非常適合塵蟎、黴菌生長

別怕!讓我們用淨毒五郎的衣物驅蟎噴霧
製造出不利於塵蟎生長的環境吧!

我一開始也很納悶
為什麼叫做驅蟎噴霧而不是殺蟎噴霧?🤔
後來我看到淨毒五郎這段解釋就恍然大悟啦!
----------------------------
#以驅蟎代替殺蟎
有塵蟎過敏的人都知道,主要造成過敏的原因來自於塵蟎的屍體、糞便,
而不是正在你棉被裡面爬來爬去的成蟲
如果這時候選擇殺死牠會發生什麼事呢?
沒錯!可能會把塵蟎屍體留在棉被上,讓過敏症狀變得更加嚴重🤢
而且環境依舊是塵蟎愛的地方,所以仍會有殺不完的塵滿!
我們認為最好的方式是:在「#經過清洗曝曬、或是 #以吸塵器徹底清潔後」,
再使用我們的衣物驅蟎噴霧3-4天噴灑一次,噴灑在塵蟎最喜歡藏匿的織品上,
例如棉被、沙發、布偶(因為裡面總有滿滿的食物!)
在長久的使用下,塵蟎就不敢靠近這個區域了🥰
----------------------------

毒家的驅蟎噴霧,已經是我家不能缺少的一品,
我在客廳、房間都放一罐,用吸塵器吸乾淨後>就會立馬噴灑
才算完成整個清潔流程衣物換季時也很需要噴一下
主要成分為薰衣草、檸檬、尤加利等天然植萃成分
所以噴灑後,空間也會變得很清新
雖然對我們來說,噴出來是香香的氣味,
但卻是蟎蟲最討厭的氣味!
依照檢驗報告顯示,持續使用超過6周,可達到99%驅蟎效果!
(後續新版驅蟎噴霧更新效果為>>噴完24小時後可以達到9成驅避效果)

重點是成分不含西藥或殺蟲劑,
連家有蠶豆症患者、孕婦、小孩或寵物都可安心使用
必須長期持續使用才打造低蟎環境

您們有聽過塵蟎臉嗎?
有時候粉刺痘痘長不停
原來是塵蟎造成的😰😰😰
別讓您的臉變成塵蟎細菌的溫床
所以別忘了!枕頭也要套 驅蟎保潔枕墊
用薰衣草、檸檬、尤加利,
打造出塵蟎不喜歡的生活環境!


注意!!! 防蟎枕套約3個月就要替換,不能重複使用哦!


如果您常常揉鼻子,打噴嚏,流眼淚,
覺得這裡癢那裡也癢?
您一定要試試看淨毒家的驅蟎系列!
安全/有效/天然

除臭噴霧(微風/無香/春日/翠柏)
家裡有養寵物的捧友們
應該都聽過淨毒家的除臭很厲害!
其實我最近處理阿暖哥便便時,
也深深有感,除臭噴霧,實在是太厲害了![]()

生活中其實也滿多異味!
像冰箱菜味、廚房油煙味、五味雜陳的洗水槽
寶寶尿布、寵物大小便(貓砂)、垃圾桶飄出異味、
吃完烤肉火鍋的油煙味,煙味,嘔吐味等等............
😐人生有太多不能忍受的異味😐
沒想到,就這樣噴一下(好啦有時候很臭不只一下才有效)全部煙消雲散!

淨毒家的除臭噴霧,
雖然分成這四種氣味-微風/無香/春日/翠柏
但它不是用香氣去壓臭味
而是利用植物酵素進行生化分解轉變
選用IFRA認證的低敏配方香料
比精油更不容易造成敏感
由於是植物萃取成分,所以噴灑在空氣中時
無論是小小孩或是毛小孩
聞到或是觸碰到都沒問題👌
只是對於香氣或是氣味較敏感的人,可以選擇無香
或是我自己習慣在廚房及微波爐/烤箱/氣炸鍋
等電器中使用時,選擇無香除臭噴霧
也可避免香味和食物再次交織混雜

但有些地方就很適合有香氣的除臭噴霧
例如鞋櫃、鞋子、洗水槽、冰箱(見仁見智)
其中這三種香調我個人最喜歡春日![]()
微風 -較清新感的氣味
春日 -微甜的橙花味(花香調)
翠柏 -聞偏木質調的香氣加入檸檬點綴
雖然成分都是可接觸肌膚,
(甚至可加入到化妝品裡面的成分),
但請不要對著毛小孩噴喔
大部分寵物不喜歡這樣不舒服的感覺

而且不止除臭還能有效抗菌
像安全帽不太能情節,
但一到夏天就悶出油臭味!
這時候除臭噴霧就派上用場啦!![]()

等了好久!終於等到淨毒五郎推出
廚房去油污清潔慕斯
市面上雖有許多同類型商品,
但有的氣味刺鼻,有的不夠天然環保
有的效果不彰!那淨毒五郎的呢?

五郎一貫作風,有效也要夠天然!
所以這罐廚房去油污清潔慕斯
使用的也是天然介面活性劑,
通過ECOCERT有機認證的成份!
加入去油雙酵素-蛋白酶酵素與脂肪酶酵素
採好吸附溶解油脂的慕斯型態,
無死角使用於廚房抽油煙機/瓦斯爐上

因為採用食器級清潔劑植物原料
所以,也可安心使用於氣炸鍋、烤箱、微波爐等小家電

💯植萃清潔成分-不傷人體和環境!
💯天然去油酵素-更有效對抗頑固重油汙!
💯綿密幕斯型態-全面吸附髒汙零死角!
先來幫大家測試一下清潔氣炸鍋的效果

這是我氣炸胡椒餅後的慘況
鮮美的肉汁和油脂,
不負眾望地被氣炸鍋給全盤逼出


依照說明噴上去油慕斯等待20分鐘


噴的時後沒有聞到甚麼特別的氣味
約莫20分鐘後...幕斯逐漸溶解了

接著進行清洗,發現不太需要用到菜瓜布刷洗
就可以用水把油汙沖掉
效果真的挺不錯的耶👍👍👍

不過烤盤部分則需要用海綿帶一下
不須太費力就能將油汙洗淨!

它的去油原理就是利用
雙酵素-蛋白酶酵素與脂肪酶酵素
對油汙進行包覆分解所以噴上後需要等待一段時間讓成分作用

那天心血來潮煎個雞腿排,
沒放任何油,也噴的到處都是

還好有廚房去油污清潔慕斯
煎完噴一噴,吃完飯剛好來驗收成果

過了一段時間來看泡沫都逐漸溶解了

用抹布擦拭一下就清潔溜溜啦

使用前/使用後
清潔廚房就是這麼輕鬆不費力
所以煮婦們!一定要備好這罐廚房去油污清潔慕斯
讓老公們沒有理由不做家務!![]()

-----------------------------------------------------------------------------------------------------------------------------------------------------------
去油污廚房清潔慕斯使用Q&A
Q1:廚房清潔慕斯可否用來清洗油污刷不掉的鍋子或廚具?
產品成分皆為植物來源的溫和原料,且使用食品洗劑的原物料,
因此用來清洗重油污的食器上也可以,即時不小心殘留吃到也無慮。
但還是建議先使用去油汙慕斯清潔後,再用中性的洗碗精進行二次清潔比較好喔!
Q2:用量大概要噴幾下?
在有油污的地方,覆蓋一層慕斯即可,若油污太厚,無法一次清潔乾淨,可以針對局部再次清潔。
Q3:使用時是否有濃厚的化學藥劑味?
產品本身沒有添加額外的香精,加上為了有效清潔頑固油污,添加濃度較高的清潔成分,
因此會有較重的植物來源清潔劑原料味,若對氣味較敏感者,建議使用時可以戴著口罩。
Q4:使用去油污廚房慕斯時是否需要戴手套??
產品多以植物原料成分組成,但清潔成分濃度較高,因此肌膚敏感者,建議戴手套使用。
Q5:去油污慕斯有什麼材質上不能使用嗎,鋁合金材質是否可以使用呢?
去油污慕斯是弱鹼性唷,基本上要看材質是否適合弱鹼性,鋁合金適用酸鹼值7-9是ok的,鋁合金比較怕強鹼。
-----------------------------------------------------------------------------------------------------------------------------------------------------------
回目錄
益菌生嬰兒洗髮沐浴慕斯
我一看到這罐就會一直想到
我用的是益生菌😆
不過事實上,用這罐幫寶寶洗澡
可以促使好菌變多,就像我們都知道
腸道需要很多好菌-益生菌一樣的概念

什麼是益菌生呢?
簡單說好像是一種防護罩!
當皮膚表面壞菌變多時,就很容易出現一些皮膚問題
例如紅腫過敏發癢之類的症狀
使用添加益菌生的清潔商品,可以促使好菌生長
進而抑制壞菌生長,就可盡量降低皮膚問題囉!

這罐益菌生嬰兒洗髮沐浴慕斯裡面,
並沒有其他不必要的添加,
例如香料、酒精、塑化劑、色素、甲醛、皂鹼、防腐劑..等!
94.9%都是安全的天然成分來源
所以敏感膚質寶寶也可以使用
起泡劑是ECOCERT認證的胺基酸界面活性劑
所以洗完後,皮膚觸感會有點滑滑的
另外還有增添海藻精華萃取,
更滋潤保濕寶寶的肌膚喔!

很喜歡它的慕絲劑型,
因為寶寶皮膚的皺褶很多!
用慕斯更能深入這些區塊
尤其洗屁屁的時候,
真的覺得超方便的!
不用再額外起泡,就可以把屁屁洗得乾乾淨淨
也不用擔心刺激到寶寶最嫩最敏感的私密肌膚

而且它的泡泡綿密度很夠
不太容易散開,通常我都會擠兩下到澡盆
但泡泡也不會很快就化掉
所以就可以一邊泡澡一邊洗,很方便!


一罐從頭到身體都可以使用,
洗完也不用特別再用大量清水沖洗
因為是異位性皮膚炎或是過敏肌膚質都可以安心使用的成分,
讓寶寶洗了又可以增加皮膚的好菌
就比較不容易,有皮膚問題

雖然沒有香味,但我覺得如果喜歡香味,
可以用有香氣的乳液就好
洗澡的東西,比較容易碰到眼口鼻,
還是沒有香精比較好

如果您也想,感受胺基酸和海藻精華萃取的好
淨毒五郎也有推出胺基酸抗菌洗手慕斯
讓我們每次洗手,除了清潔,更能有效除菌!
並且不帶走水分,用海藻精華萃取滋潤保濕手部肌膚

使用衛福部頒訂抗菌成分繖花醇,有效去除雙手病菌。
Ecocert認證醣基海藻糖,滋潤雙手,洗後不乾澀。
日本進口胺基酸成分,敏感肌也適用的清潔成分。
慕斯設計,綿密好搓好沖洗。
醫師專業推薦,成分安全,有效抗菌。
滋潤力實測
有效增加肌膚含水量 24 %

一貫符合居家美學的簡約包裝

擠出來是很綿密紮實的泡泡


慕斯劑型不須起泡也更能深入指縫
現在洗手真的是一件很重要的事情
所以可別輕忽了"洗手品"的選擇

洗完不乾澀,香味也滿持久的呢!

說到洗手就想到討人厭的水垢
淨毒五郎在2022/1月也推出了新產品
除水垢浴室清潔劑
我家這邊的水質偏硬
所以很容易有水垢,
真是迫不及待要來試試看它的效果!

我家的水龍頭和旁邊的石磚上
時常都是這樣狀態
看起來就是舊舊髒髒很討厭


依照使用說明噴上後靜置5分鐘
噴出來,沒有甚麼惱人的刺鼻味
甚至要很靠近聞,才會聞到一點點柑橘的味道
網頁上標示氣味對孕婦無影響,
但3歲以下兒童因為支氣管組織尚在建立,
對於橘油內的檸檬稀容易造成刺激,
故還是不建議在小孩在的時候使用
蠶豆症患者也可安心使用(不含樟腦)

石磚上也可以使用
(成分可使用在磁磚,金屬、玻璃、大理石上)
但是在電鍍的金屬表面上,
需要先在邊角測試沒問題後再使用
也不建議使用在壓克力材質上!

接著用濕抹布擦拭一下
果然輕輕鬆鬆就去除了水垢

石磚上的水垢也去除了

有了這樣的成果後
接著來處理更多水垢的蓮蓬頭及浴廁玻璃門

真是惱人的水垢無所不在

這個部位最嚴重
先來處理這個位置,順便做一個使用前後的對照

一樣噴上後靜置,
因為這邊比較嚴重我大概停留了10分鐘

玻璃門也先處理一小角

接著用水沖掉真的變得乾乾淨淨耶!

看看這對比照

這玻璃上的水垢真的很難照清楚
但這樣一比就知道,有種眼睛一亮的視覺感啊😆

而且不只能去除水垢,
添加柑橘精油,還可以去除髒汙!
有水垢真的會讓浴室的人生看起來是黑白的
但有了這罐除水垢浴室清潔劑
您我都能變成居清高手啊!

後續淨毒五郎又推出了黃金鑽石海綿
可以搭配除水垢清潔劑/去油汙廚房清潔劑一起使用
甚至不沾清潔劑,只需沾水也能去除簡易的汙垢

由於採用德國來源特殊原料
不會刮傷表面造成刮痕,所以可以使用在
玻璃、大理石、爐具及不鏽鋼材質上

像浴室玻璃簡單的水垢就可以在洗完澡後
用水簡單清洗一下

洗手檯面也可以放一塊
隨時清洗一下汙垢
不同於一般菜瓜布容易摩擦出細小刷痕
導致更容易藏汙納垢

簡易清理後,水龍頭也能變得亮晶晶的
防疫生活中不可缺少的就是酒精啦
但除了酒精外,我們有更溫和安全的選擇
那就是使用物理性抗菌-長效抗菌噴霧+Plus升級版
物理性抗菌 無毒無污染
無香料無精油 溫和不刺激
天然保濕成分 減緩發紅及紅斑
在人體肌膚形成保護膜,
達到24H的長效抗菌效果
使用物理性的抗菌機制
保濕、安全、0污染
小小孩、孕婦、蠶豆症患者也適用

什麼是物理性抗菌?
就是以帶電分子破壞細胞壁,形成24H抗菌防護罩,有效對抗環境細菌!
這罐非常適合肌膚敏感,像噴酒精容易過敏、泛紅的捧友
或是長時間在外面,不想一直補噴酒精的捧友
因為經過實驗室檢驗證實
噴了之後有長達24H的長效抗菌效果,忘記補噴也還是有一定的防護力!
但洗手後,就還是會建議重噴喔!

成份溫和不刺激,因此可以當作寶寶的乾洗手
(噴在寶寶手上後須等至少30秒後再放寶寶自由活動)

學齡兒童,上課也很需要帶一罐

也可以噴在物品上,使用後不用特別擦拭,
雖然不小心吃到沒關係,但產品是非食用性,還是要避免直接食用!


像是很多細菌的手機,噴完後靜置30秒後
擦或不擦都可以不過一般會想擦掉吧😅

很髒的鍵盤,也需要再使用前後滅菌一下

從外面回家時會碰到的把手/開關
也很需要滅菌

寶寶常常會接觸到的餐椅

甚至玩具桌/玩具也都可以使用
但若是噴在寶寶嘴巴會接觸的玩具
噴完建議要擦拭比較好,
因為長效抗菌噴霧是不可食用的

雖然不小心吃到沒關係,
但產品是非食用性,還是要避免直接食用!(很重要)

小小一瓶100ML攜帶方便,出門在家都可以使用
利用專利的有機矽抗菌劑及衛福部頒訂的有效抗菌成分達到高效防護的效果
使用物理性的機制,以帶電分子破壞細胞壁,形成24H抗菌防護罩,有效對抗環境細菌

這邊也有一些常見的Q&A可以參考
-----------------------------------------------------
長效抗菌噴霧+Plus升級版使用Q&A
Q1:請問長效抗菌噴霧可否用於新生兒/孕婦/寵物存在環境中?
是可以的。長效抗菌噴霧在設計時是使用安全且符合法規濃度製成,抗菌成分通過衛福部認證核可,可以放心使用。
Q2:請問長效抗菌噴霧是否含有精油成分?
此產品並不含有精油、酒精成份。
Q3:請問長效抗菌噴霧抗菌保存期限、抗菌效力多久?
保存期限為3年、經第三方公證檢驗,使用後抗菌效力可達 24 小時。
Q4:請問長效抗菌噴霧噴完怎麼清?
長效抗菌噴霧直接噴灑於物品、肌膚等欲達到有效抗菌防護作用之地方,使用後不需沖洗。
Q5:請問蠶豆症是否可使用長效抗菌噴霧?
是可以的。長效抗菌噴霧在設計時,並不含有樟腦等會對蠶豆症患者造成影響的部分,可以請您放心使用。
Q7: 皮膚有傷口可以使用嗎?
每個傷口狀況不一,且商品跟藥品作用仍有差距,建議還是盡量避免噴灑在傷口處。
-----------------------------------------------------
回目錄
居家抗敏益生菌噴霧(已停產)
這是一罐可以使用在環境當中,
用來改善環境的過敏原的噴霧!

一開始我看到這支商品時
也有點困惑,它和衣物驅蟎噴霧又有甚麼不同呢?
「居家抗敏益生菌噴霧」主要是使用在環境中

產品通過ATCC跟EFSA認證,最安全可食用之菌株。
有效分解致病菌膜,抑制壞菌生長。
針對塵蟎、糞便與屍體、動物毛髮蛋白質等過敏原,可有效去除。
針對寵物毛髮造成的過敏狀況也適用,可以有效分解造成過敏的蛋白質。
但「驅蟎噴霧」主要是針對織品上的塵蟎進行作用,
利用氣味驅避蟎蟲,形成蟎蟲不喜歡的環境,降低蟎蟲的孳生。

如果環境中有其他過敏原像是動物毛髮蛋白質等等,
會建議使用居家抗敏益生菌噴霧,降低改善環境的過敏原

兩者作用及成分不同,是可以交替使用的
「居家抗敏益生菌噴霧」像是大掃除後總是會有較多過敏原跑出來,
這時候就可以噴灑在居家環境中,每天定時使用!
「衣物驅蟎噴霧」主要是噴灑在織品、沙發、床鋪上,3天使用一次!
例如寶寶遊戲區有放娃娃,也比較可能有過敏源,
這時候也可以噴「居家抗敏益生菌噴霧」
或是家中有養寵物,
也可以每天定時噴灑「居家抗敏益生菌噴霧」
讓環境中不易滋生細菌,並且有效分解造成過敏的蛋白質

羽絨專用洗劑
這是一罐專為羽絨而生的洗衣精!
可以避免與羽絨結球/還可以幫助抗菌去味!

過去只要購買羽絨被/羽絨外套,
廠商都會建議我們送乾洗,其實不是不能水洗和機洗
而是用一般洗劑來洗這些羽絨製品
對它們就是一種漸進式的傷害
您可能會發現,怎麼越洗羽絨越不蓬鬆了?
感覺保暖度也變差了?甚至因為冬季潮濕氣候讓羽絨產生的異味
也沒有因為洗過而改善?
這就是為什麼會催生出這罐「羽絨專用洗劑」的原因囉!
淨毒五郎與擁有超過50年經驗的專業羽絨研發團隊
EasyLife 十月被 合作開發出 #專為羽絨設計的專用洗劑#

除了洗後羽絨不結球外,還可維持羽絨的蓬鬆度
因為裡面有添加3倍護纖成分
可以保留羽絨的天然油脂
因此也就不會降低羽絨的保暖度喔!

因為冬季潮濕氣候,吸水受潮的羽絨外套
也可以透過這瓶「羽絨專用洗劑」的鋅離子除臭技術
從根本將臭味消除!

除了去味外!還可以抗菌!
是不是一舉兩得太棒了!

最近買了一條石墨烯的被子
蓋起來不輸羽絨的輕柔,暖的快,蓄熱度也更好!
但廠商不建議水洗,不過看到淨毒五郎這邊的說明
我也決定要來勇敢清洗了!
Q3:可以洗石墨烯被、羊毛毯嗎?
石墨烯是新型碳奈米材料,是可水洗的。若被芯是整片填充成一體成型的水洗不走位變形,按照使用說明正常使用羽絨專用洗劑是可以的。
本產品不含蛋白分解酵素,如果您的羊毛織品洗標上標示可以水洗,即可以參照洗標上的洗滌方式,使用我們的羽絨專用洗劑呦!

這部分我也和廠商確認過囉!確實是一體成型的製程
所以等天氣好一點,我就要來洗我的石墨烯被被了😁

在這之前,我先來洗看看老吳這件穿了很久的羽絨背心
他整個就是念舊到,不肯買新的替換!
越來越不蓬鬆+有羽絨的異味,
在他這件陳年背心上都有!

因為只有要洗這件,就用手洗的方式處理
我按了兩下,接著用10倍的水做稀釋

接著浸泡約15分鐘

再用按壓的方式加強清洗接著拿去低速脫水
注意!不能用擰乾的方式喔!
低速脫水後再曬乾/烘乾,才是正確的洗滌方式!

洗完後,感覺羽絨有比洗之前蓬鬆一些
異味也真的都被去除了!

不過也有可能是因為烘乾的關係
所以看起來比較蓬鬆
但至少去味又能抗菌!
之後這樣洗羽絨,輕鬆又安心!

護纖成分添加(小麥蛋白) #為天然羽絨護髮
鋅離子除臭技術(有效去除鴨絨異味) #從根本將臭味消除
親膚溫和不刺激(植物界面活性劑) #不傷手最安心
天然抗菌減少細菌(葡萄柚果萃取)#去味抗菌一次完成
這罐羽絨專用洗劑,真的是家家必備品啊!


除臭地板清潔劑
這是一罐兼具除臭、抗菌的寵物友善地板清潔劑
且適用於各種地板材質!

很多家中有養寵物的朋友
總會有臭味的問題,過去常會使用漂白水
除臭殺菌,但過程中刺鼻的味道人就覺得難受了
更何況是比我們更接近地板的毛小孩
所以淨毒五郎就推出了這罐毛小孩專用的「除臭地板清潔劑」
它是透過葡萄柚果萃取來減少細菌和臭味
其實不只對抗寵物臭味有用,
就連廚房難解的臭味也有效耶!

而且它適用於各種地板材質
還有添加成分能減少灰塵附著
所以沒有養寵物的朋友,
也可以把它當作一罐
有去汙力,除臭抗菌的地板清潔劑使用!

就是一罐有添加專利除臭成份
和衛福部頒訂溫和抗菌成分的地板清潔劑

像家裡有這種皮小孩,喜歡在地上坐著玩
撿地上的東西吃,也需要保持地板乾淨啊!

用量真的很省,這樣一瓶蓋約10CC就可以
加1公升的水進行稀釋

也可以稀釋成噴霧,坐物品擦拭或是小範圍的噴灑
/稀釋後建議三天內使用完畢/

加進水中,沒有甚麼泡泡
也沒有葡萄柚的氣味
就是很淡很淡的清潔劑氣味

擦拭後也不用再用清水二次擦拭
不過這邊有看到這個問題
Q4:擦拭後寵物可以舔地板有影響嗎?地面若未乾會有影響嗎?
無影響,皆可以安心使用。但需注意犬貓直接飲用原液可能有代謝不良與中毒的風險,
請使用者確實按比例稀釋,並盡量乾燥後再讓寵物落地。

有獸醫師幫毛小孩背書
但其實不論是 家中有毛小孩或是比較容易接觸地板的嬰幼兒
又或是家有腳臭成員困擾的家庭都非常適合這罐除臭地板清潔劑!

不要被名字侷限了!
它就是一罐有添加專利除臭成份
和衛福部頒訂溫和抗菌成分的地板清潔劑
所以每個家庭都適用!
廚房常常開伙的家庭
也很適合用這罐,定期清潔喔!

NEW深層除黴凝膠
強力拔除頑固黴根

這項新產品厲害了
不同於市面上同類型商品
打開居然是"無味"!不是無香喔!是無味
就算我拿很靠近聞,也真的聞不到任何一點味道!
原來是用凝膠包覆隔絕原料氣味
難怪一點味道都沒有!
接著當然要實際試驗看看它的效果!
首先先到有矽利康膠條的浴室或是廚房看看
因為這些地方正是最容易發黴的區塊
不負眾望!果然在娘家廚房洗水槽旁邊找到了目標!


依照指示
"將要除黴的區塊擦乾後>>再把除黴凝膠塗上"
等待30分鐘後來驗收成果


30分鐘過後,"哇哇哇!這也太給力了吧!"
剛剛看到的那些黴斑就這樣消失了
我甚至連刷洗都沒有還真是有點僥倖的感覺哈!


接著是我家吸在磁磚上的吸盤
這處的黴斑,真的看得我頭皮發麻耶!

因為這區真的有點嚴重
所以決定滴上凝膠後,等待隔天再來驗收
滴凝膠的時候,發現這凝膠的黏著性不錯
就算是這麼彎的角度,也沒有半點滴落

隔天早上,居然就變成了這個樣子
我都還沒沖水就白了一片
真的是令人感動的除黴效果啊!

只能說這真的是我用過最有效的除黴凝膠
而且"完全無味"彷彿感覺不到它的存在!
再來看一次療癒的Before / After瞬間



使用方式簡單/效果明顯甚至完全不需要刷洗!

除了除黴還可抗菌阻止再度發黴的作用
最重要的是
淨毒五郎擁有獨家技術
可減緩產品的降解度,
因為這類型商品,雖然有保存期限
但功效很容易隨著時間遞減
但淨毒五郎的除黴成分,是可以維持兩年功效的喔!

除了成分有效
淨毒也選了很不錯的容器
連蓋轉動開關的設計,就不用擔心搞丟蓋子了
尖嘴瓶口也更加方便使用在隙縫及邊邊角角上
真的是居家必備好物啊!


關於深層除黴凝膠能否使用在水壺的膠條廠商回復如下:
原則上,除黴凝膠不能使用在盛裝食物的容器、水瓶,或是會直接、大面積的接觸食物與飲水。
只可以使用在"配件"上,配件定義譬如為:可取下的膠條。
若矽膠吸管,為直接接觸飲品,這種就不行唷!
---
且要遵守以下條件
1、不要敷超過一小時
2、必須用中性清潔劑洗乾淨
3、若擔心殘留,可放在空氣中24小時使其揮發。
**產品特性碰到水、空氣後都會快速降解。
---
也會建議,由於只能使用在配件上
如果發霉嚴重,還是會建議評估是否直接購買新的配件做更換喔。
NEW益菌生保濕沐浴露
益菌生保濕沐浴露成分與規格

家裡有小寶寶的淨毒愛用者
應該都用過這罐
益菌生嬰兒洗髮沐浴慕斯
再複習一次什麼是益菌生呢?
簡單說好像是一種防護罩!
當皮膚表面壞菌變多時,就很容易出現一些皮膚問題
例如紅腫過敏發癢之類的症狀
使用添加益菌生的清潔商品,可以促使好菌生長
進而抑制壞菌生長,就可盡量降低皮膚問題囉!

由於寶寶益菌生沐浴慕斯大獲好評
所以淨毒歷時兩年研發,終於也推出了全家人都可以使用的
益菌生保濕沐浴露(益菌生=肌膚益菌的營養素)
這是一罐以胺基酸為基底的沐浴乳
不添加易致敏成份,如酒精、色素、皂基、Paraben防腐劑、SLS/SLES,
只給肌膚需要的,並嚴選 PH5.0 的弱酸性配方,
對肌膚溫和不刺激,是一款全家大小都適用的沐浴露
還有添加甘草提取物
可有效幫助舒緩肌膚,讓敏感肌膚也能安心使用喔!


氣味是淡淡的橙果花香調
聞起來不是很明顯的那種,
但還是有存在感,是很柔和的香氣

它的劑性不是很稠的那種

搓出來的泡泡不是很濃密
因為它的起泡劑是椰子油/小麥/玉米/馬鈴薯
等植物來源起泡劑
單單加水手搓,會是這樣的泡泡狀態
一般我大約壓兩下可以洗全身

若是喜歡多點泡泡
可以用沐浴球或是搓背巾輔助

其實一般沐浴乳洗完並不會有太明顯的感受
除非洗完肌膚摸起來特別滑或是特別乾
而淨毒家的這罐沐浴乳,洗完的膚觸就是剛剛好的保濕度
至少男生喜歡的潔淨力有,女生喜歡的保濕度也有
就是剛好滋潤保濕但不會有滑膩感的那種膚觸
但令我最最最驚訝的是洗完後的膚色,真的變的好透亮![]()
那種透亮感,彷彿像肌膚在說"這就是我目前最好的狀態!"

透亮到讓我可以清晰看到血管的顏色
這真的是我洗澡這麼多年,第一次這麼明顯的亮白感受!
也是我對這罐沐浴乳臣服的最大主因

總之這真的是一罐全家大小都適用的沐浴乳(6歲以上可用)
不會太重的香氣,聞起來舒服的橙果花香
洗後不緊繃,不滑膩!就是一種剛剛的潔淨力
非常推薦給肌膚容易乾癢,敏感的朋友!
還在使用肥皂的朋友也可參考一下沐浴乳較溫和的潔淨力
尤其淨毒家這罐沐浴乳,有添加海藻糖提高保濕度唷!

NEW控油洗髮精
控油洗髮精成分與規格

這是一罐針對台灣氣候開發的控油洗發精
其實我以前為了蓬鬆,
挑洗髮精時都會專注於"去油和蓬鬆"這樣的關鍵字
但我發現,長期下來,
只有去油可能會讓頭皮產生乾癢的狀態
淨毒這罐洗髮精,添加 3種植物來源,
在有效控油的同時,也提供了滋養成分!
甘草提取物可以有效抗油並改善氣味問題維持蓬鬆!
奈米級咖啡因可以有效滲透毛囊吸收強健髮絲韌度!
水解小麥蛋白,這是在很多護髮品上常見的成分
是一種植物性的潤髮成分可加強滋養,防止斷裂!

不添加 酒精、矽靈、SLS/SLES、Paraben類防腐劑
只給頭皮髮絲需要的成分

跟沐浴乳一樣,不是那麼稠的劑型

偏木質調的香氣聞起來有溫暖的感覺,也是淡淡的氣味

洗起來的泡泡算是濃密

洗完吹乾後,髮根也有明顯的站立感


但我去花蓮玩的時候真的太悶熱了
一整天下來瀏海還是不爭氣的分開了
不過就是不會覺得頭皮很油,還是滿清爽的
其中比較明顯的感覺是,我原本頭皮會有點乾癢的問題
但用了淨毒這罐一週後,的確有明顯的改善(但還是偶爾會癢)

對於有頭皮屑困擾的朋友,
其中的OPT甘保素,可有效抑制頭皮皮屑芽孢菌,減少頭皮屑生成
像我沒有任何頭皮屑問題,頭皮也不會太容易出油
所以不是那麼適合這罐洗髮精
但若是您有上述問題,淨毒家這罐洗髮精
就是依照台灣氣候設計給油性頭皮所使用的喔!

以上就是我的淨毒五郎使用心得
本文為本人親自試用過後的體驗心得僅供參考
產品成分及功效說明,參考商品 或官網(粉絲團)所載
全系列商品對環境及人體皆友善!
關於會接觸到肌膚的商品,
異味性皮膚炎或是蠶豆症患者皆可使用!
商品包裝簡單大方,放著家中任何地方,
都不影響您的居家美學


且瓶器採用「再生塑料」
又有填充站設置,更值得大家支持和使用喔!👍

關於MIW的大小事及選物團購
請參考:https://linktr.ee/miwmelodyinwonderland

